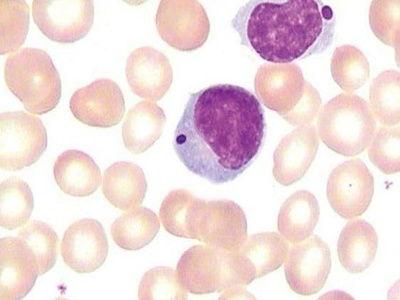
细胞里吃瓜的视频,微观视角下的生命奇观

-
上海吃瓜文化,揭秘沪上独特的社交文化现象
2026-03-0624 0说到上海,那可是个充满魅力的城市,不仅有繁华的街道,还有那独特的“吃瓜文化”。你有没有想过,为什么上海人这么喜欢“吃瓜”呢?今天,就让我...
-
跟着键盘侠吃瓜
2026-03-0622 0跟着键盘侠吃瓜,揭秘网络世界的“瓜田”亲爱的读者们,你是否曾在网络上看到那些让人捧腹大笑、又或是愤怒不已的“瓜”?没错,我说的就是那些在...
-
娱乐吃瓜视频号,吃瓜视频号带你探秘明星生活
2026-03-0621 0你有没有发现最近你的朋友圈里突然多了很多有趣的视频号?没错,说的就是那些让你捧腹大笑、好奇心爆棚的娱乐吃瓜视频号!今天,就让我带你一起深...
-
猫吃瓜情头,情头笑意浓
2026-03-0622 0你有没有发现,最近网上流行起了一种超级可爱的情侣头像风格——“猫吃瓜情头”?这可不是普通的头像,它们可是充满了趣味和创意,让人一看就忍不...
-
吃瓜大全500种,吃瓜大全概览
2026-03-0422 0亲爱的读者们,你是不是也和我一样,对美食有着无尽的热爱?今天,我要给你带来一份超级详细的“吃瓜大全500种”,让你一次性领略各种瓜果的奇...
-
小伙变成吃瓜群众,小伙的蜕变之路
2026-03-0422 0你有没有想过,一个人怎么就突然从主角变成了旁观者呢?这不,就有一个小伙子,他的故事让人不禁感叹:原来,人生就像一场戏,你永远不知道下一刻...
-
吃瓜的煤球,揭秘网络热词背后的趣味与思考
2026-03-0421 0你知道吗?最近网上有个超级火的梗,叫“吃瓜的煤球”。这可不是普通的梗哦,它背后可是有着不少有趣的故事和深刻的内涵呢!今天,就让我带你一起...
-
细胞里吃瓜的视频,微观视角下的生命奇观
2026-03-0423 0你知道吗?最近网上有个视频超级火,简直让人停不下来!它就是那个“细胞里吃瓜”的视频。是不是听起来就有点不可思议?别急,让我带你一探究竟,...
-
小新在线吃瓜
2026-03-0422 0你知道吗?最近网上有个小家伙,叫小新,他可是吃瓜界的“小达人”呢!每天上网冲浪,看到什么新鲜事,他都能第一时间跳出来,给大家分享他的“瓜...
-
哈密瓜胃疼可以吃吗,哈密瓜胃疼患者适宜食用指南
2026-03-0420 0最近天气这么热,你是不是也和我一样,一想到吃点清凉解暑的水果就心情大好呢?哈密瓜,那可是夏日里的清凉使者,甜丝丝的汁水,一口下去,仿佛整...